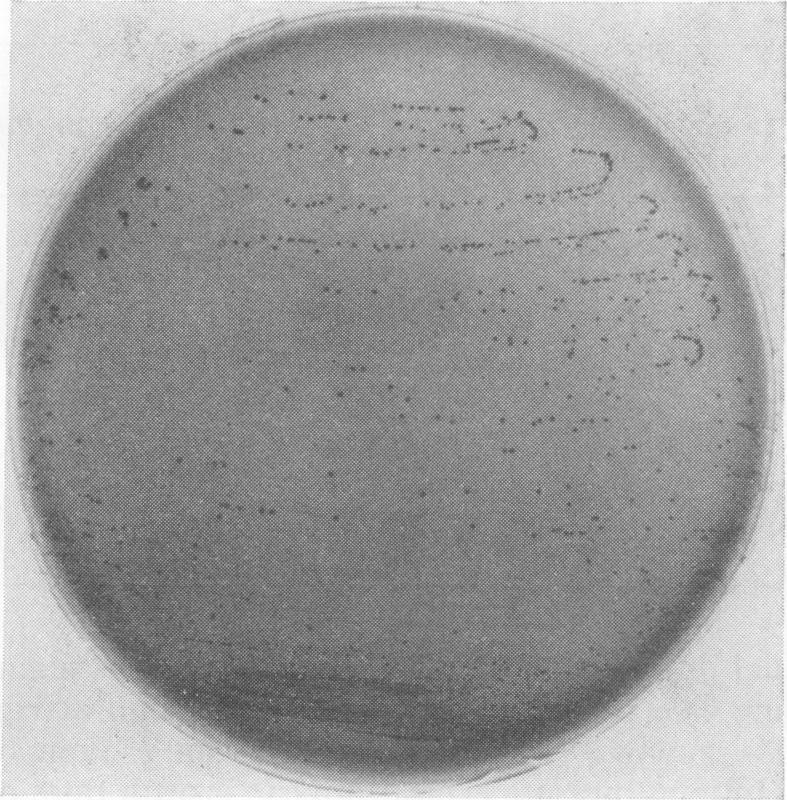
https://cdn.ncbi.nlm.nih.gov/pmc/blobs/a863/376639/b7ec47d9b6be/applmicro00099-0204-a.jpg

光滑念珠菌的实验室鉴定:在常规细菌学培养基上的典型外观。
Laboratory identification of Torulopsis glabrata: typical appearance on routine bacteriological media.
作者信息
Marks M I, O'Toole E
出版信息
Appl Microbiol. 1970 Jan;19(1):184-5. doi: 10.1128/am.19.1.184-185.1970.
Abstract
The colonial morphology of the yeast Torulopsis glabrata on sheep blood-agar is characteristic and was useful in the identification of 24% of clinical isolates.
摘要
光滑球拟酵母在羊血琼脂上的菌落形态具有特征性,对24%的临床分离株的鉴定有帮助。